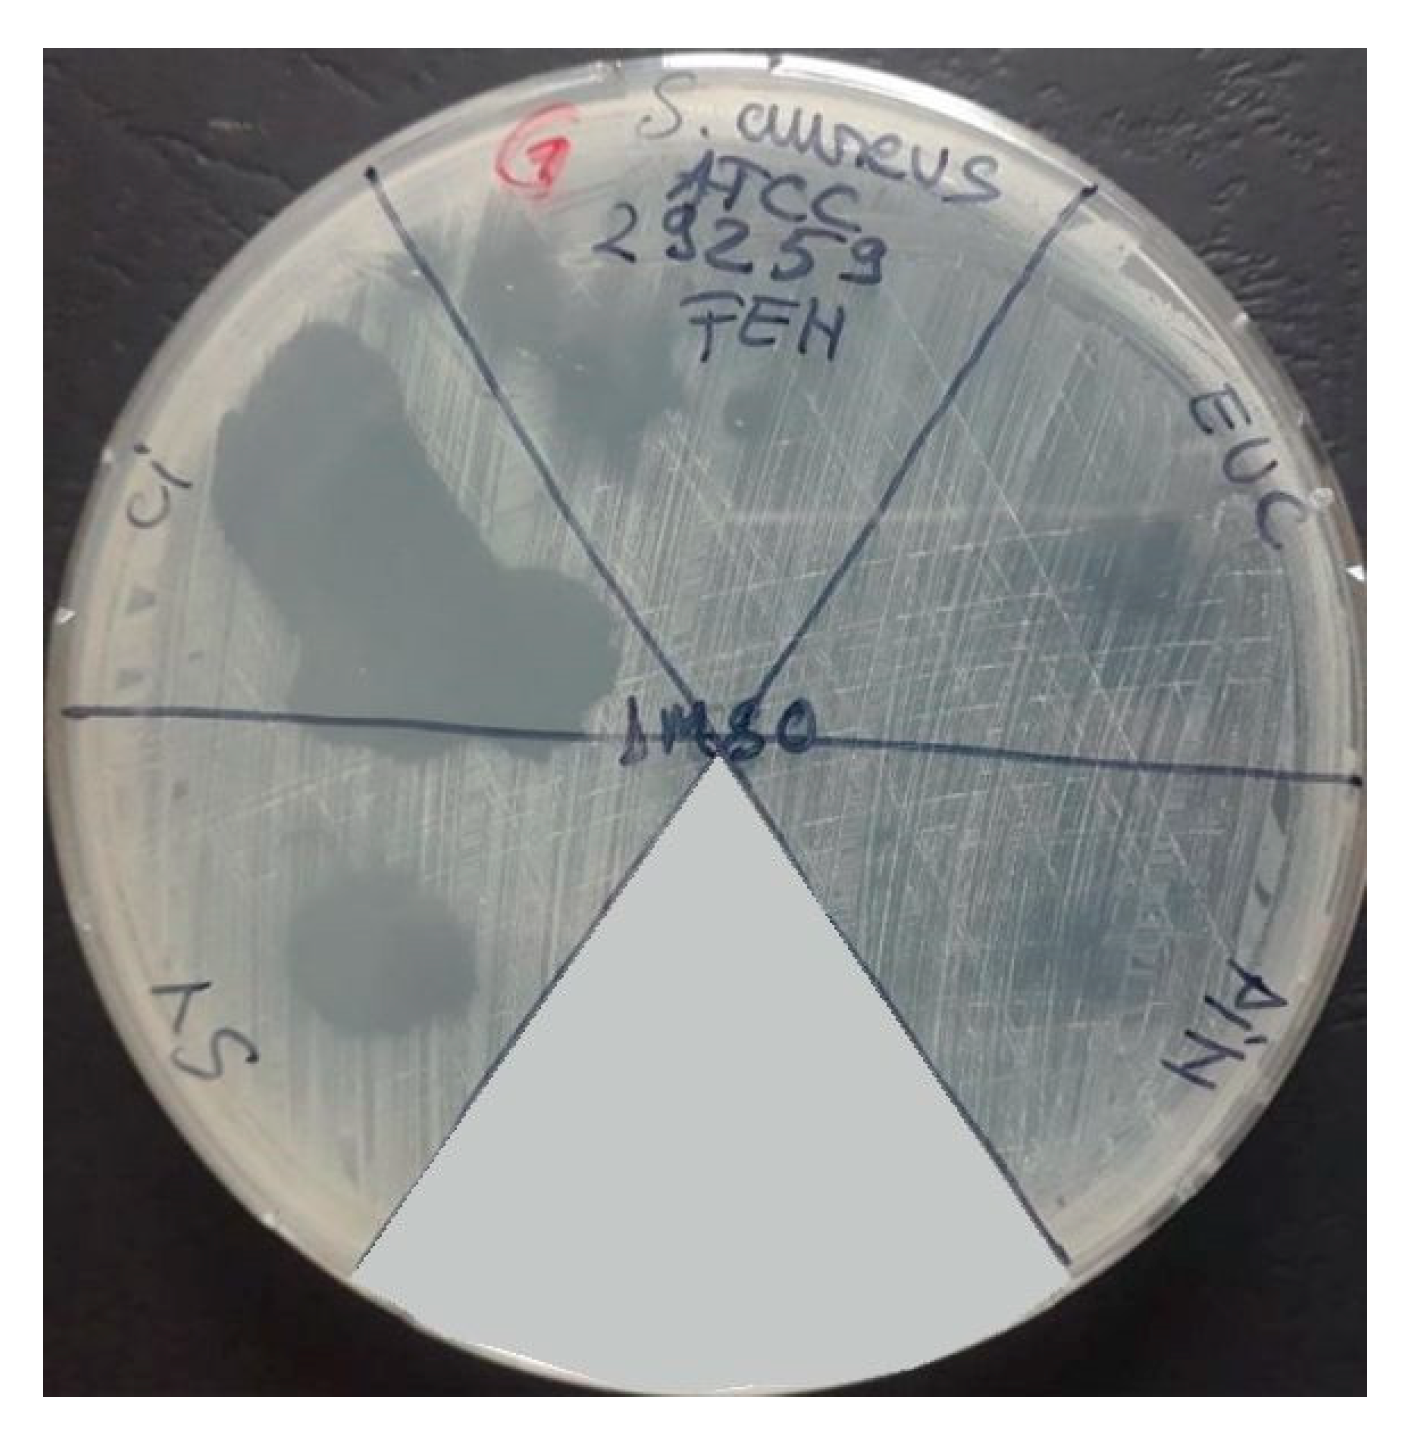
Applsci 12 09482 g003 Applsci 12 09482 g003
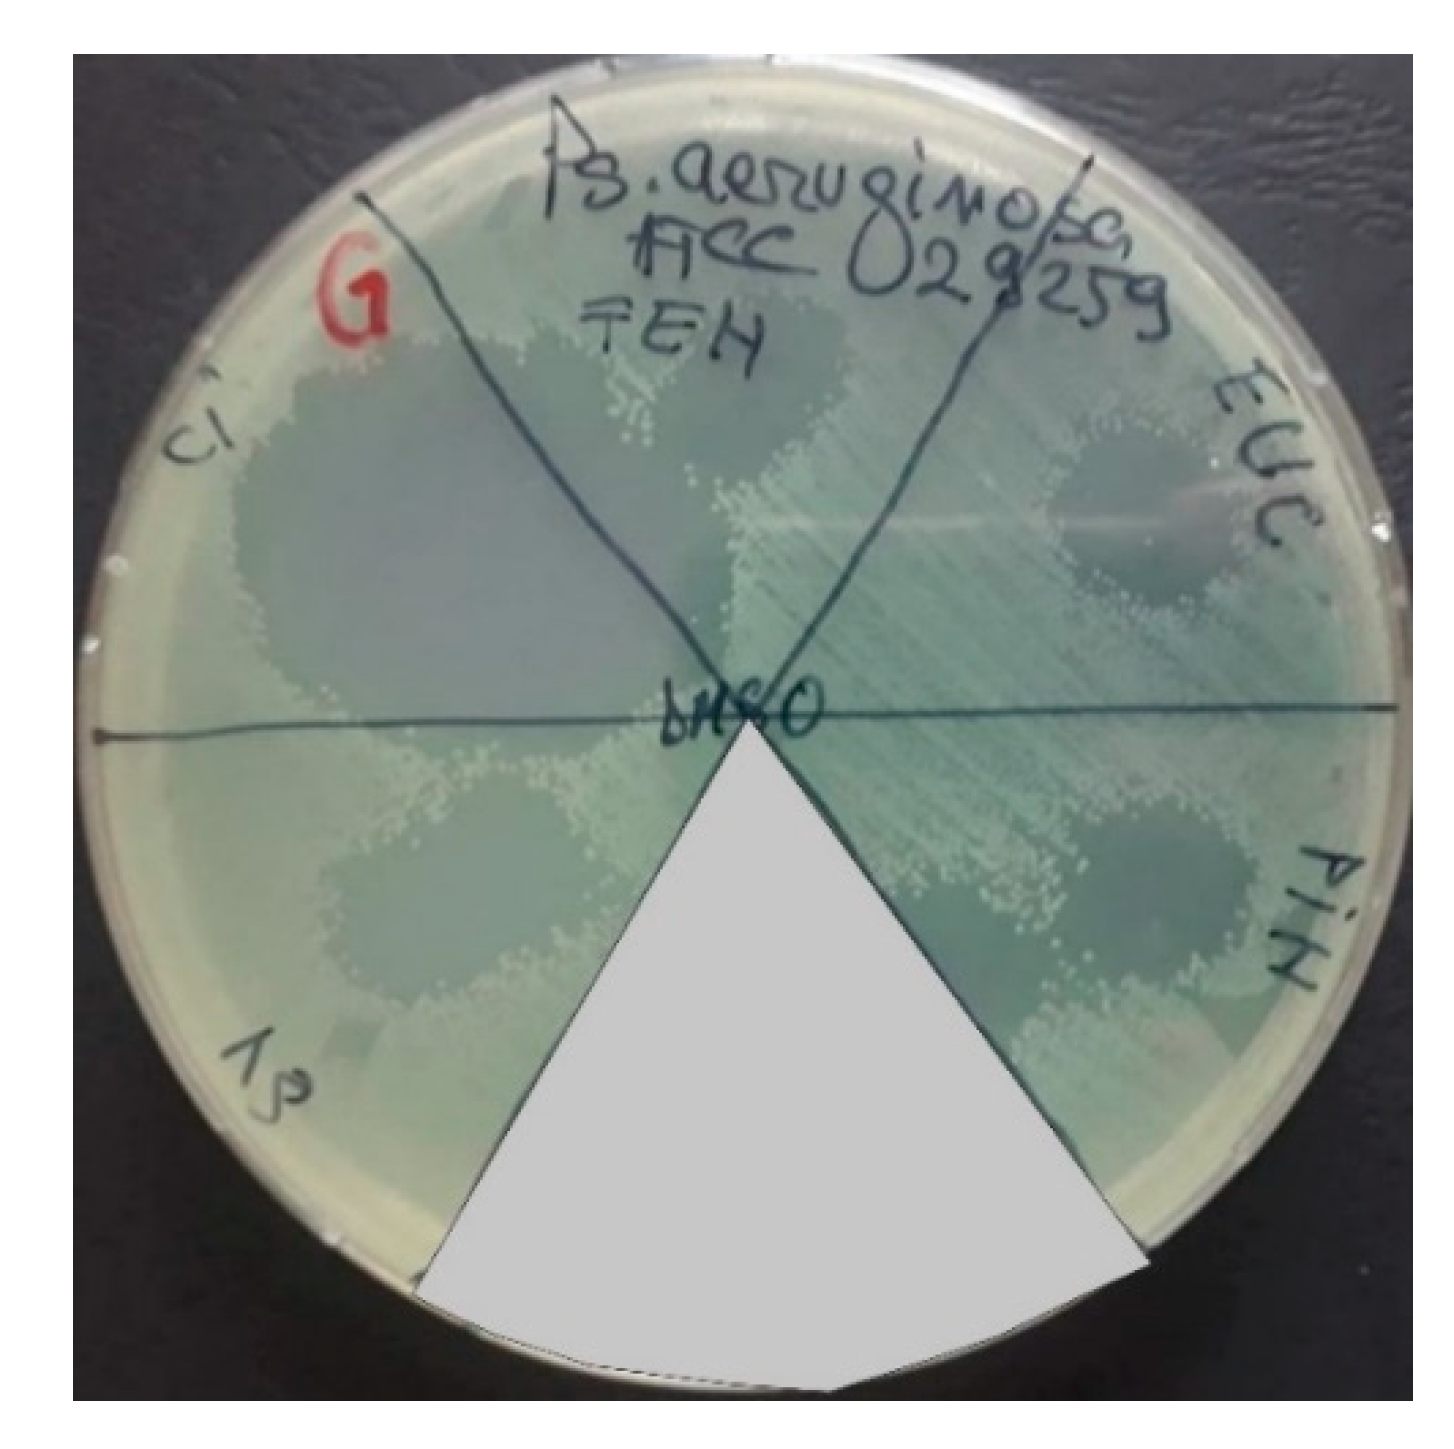
Applsci 12 09482 g004 Applsci 12 09482 g004
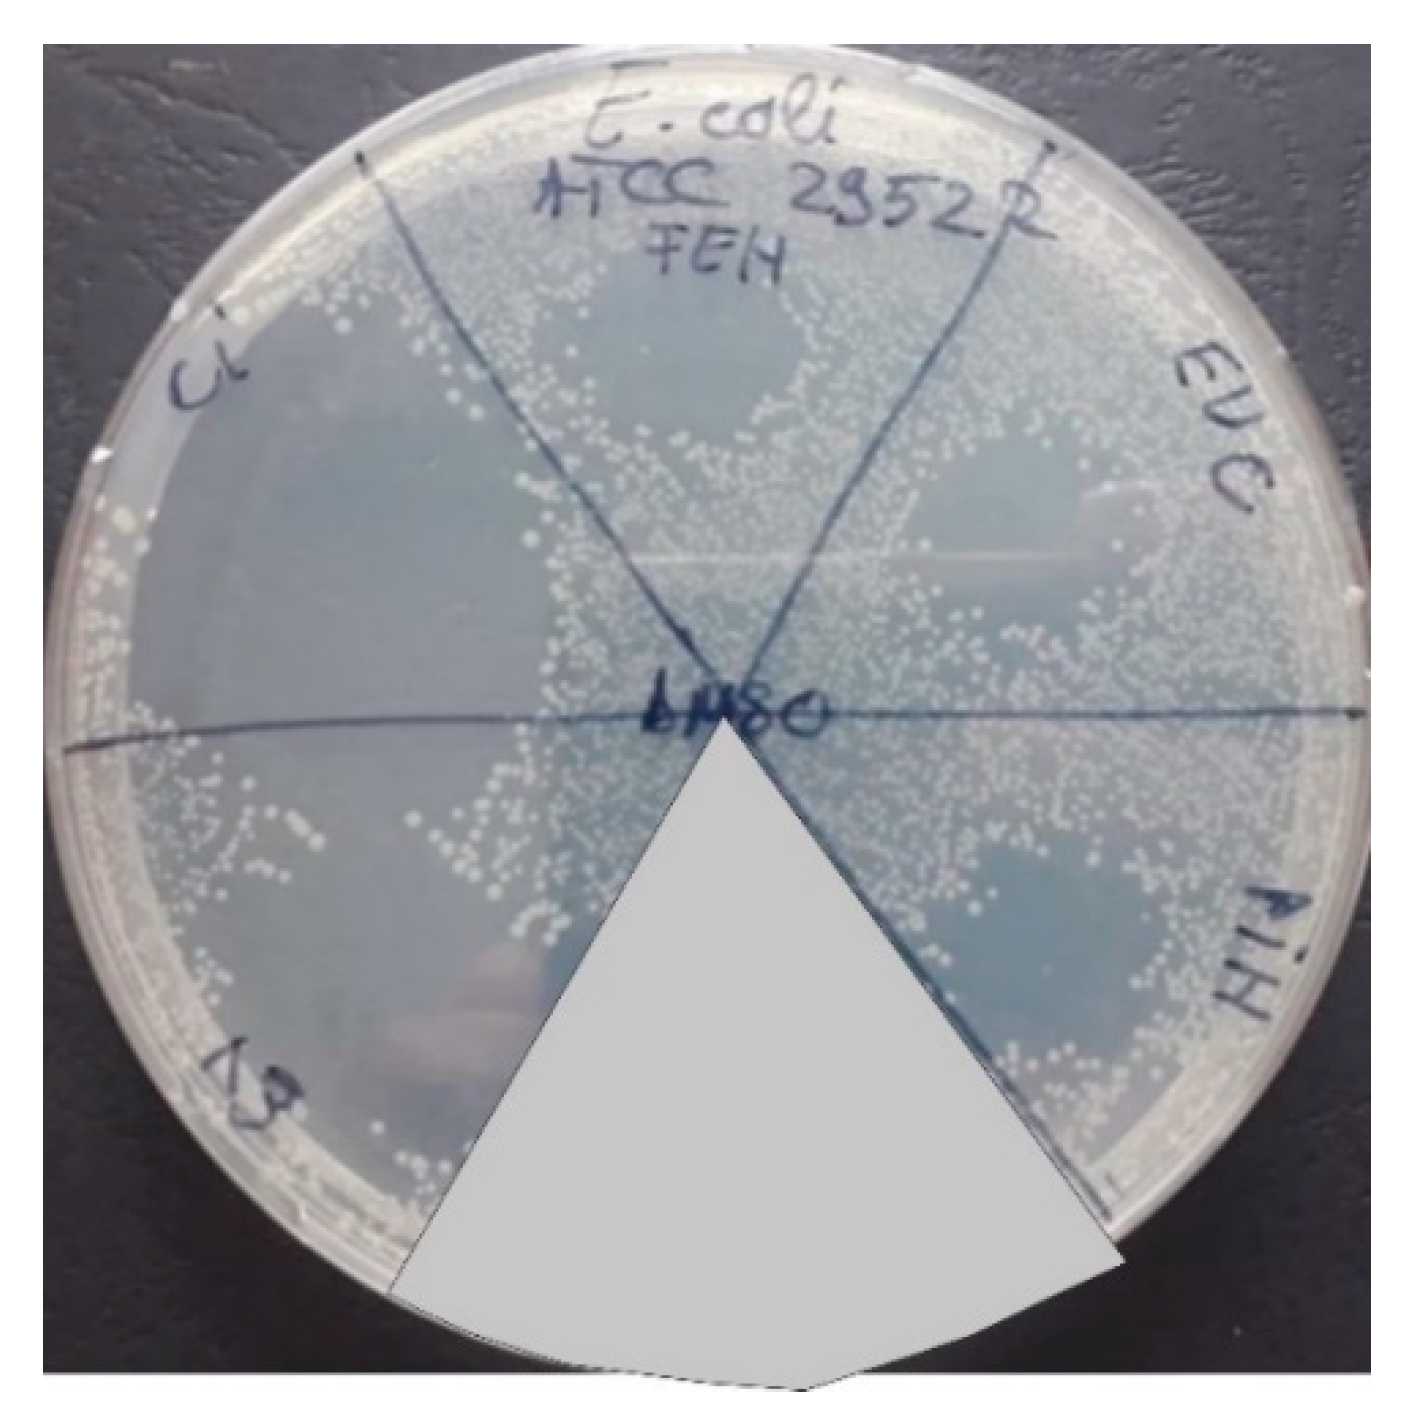
Applsci 12 09482 g005 Applsci 12 09482 g005
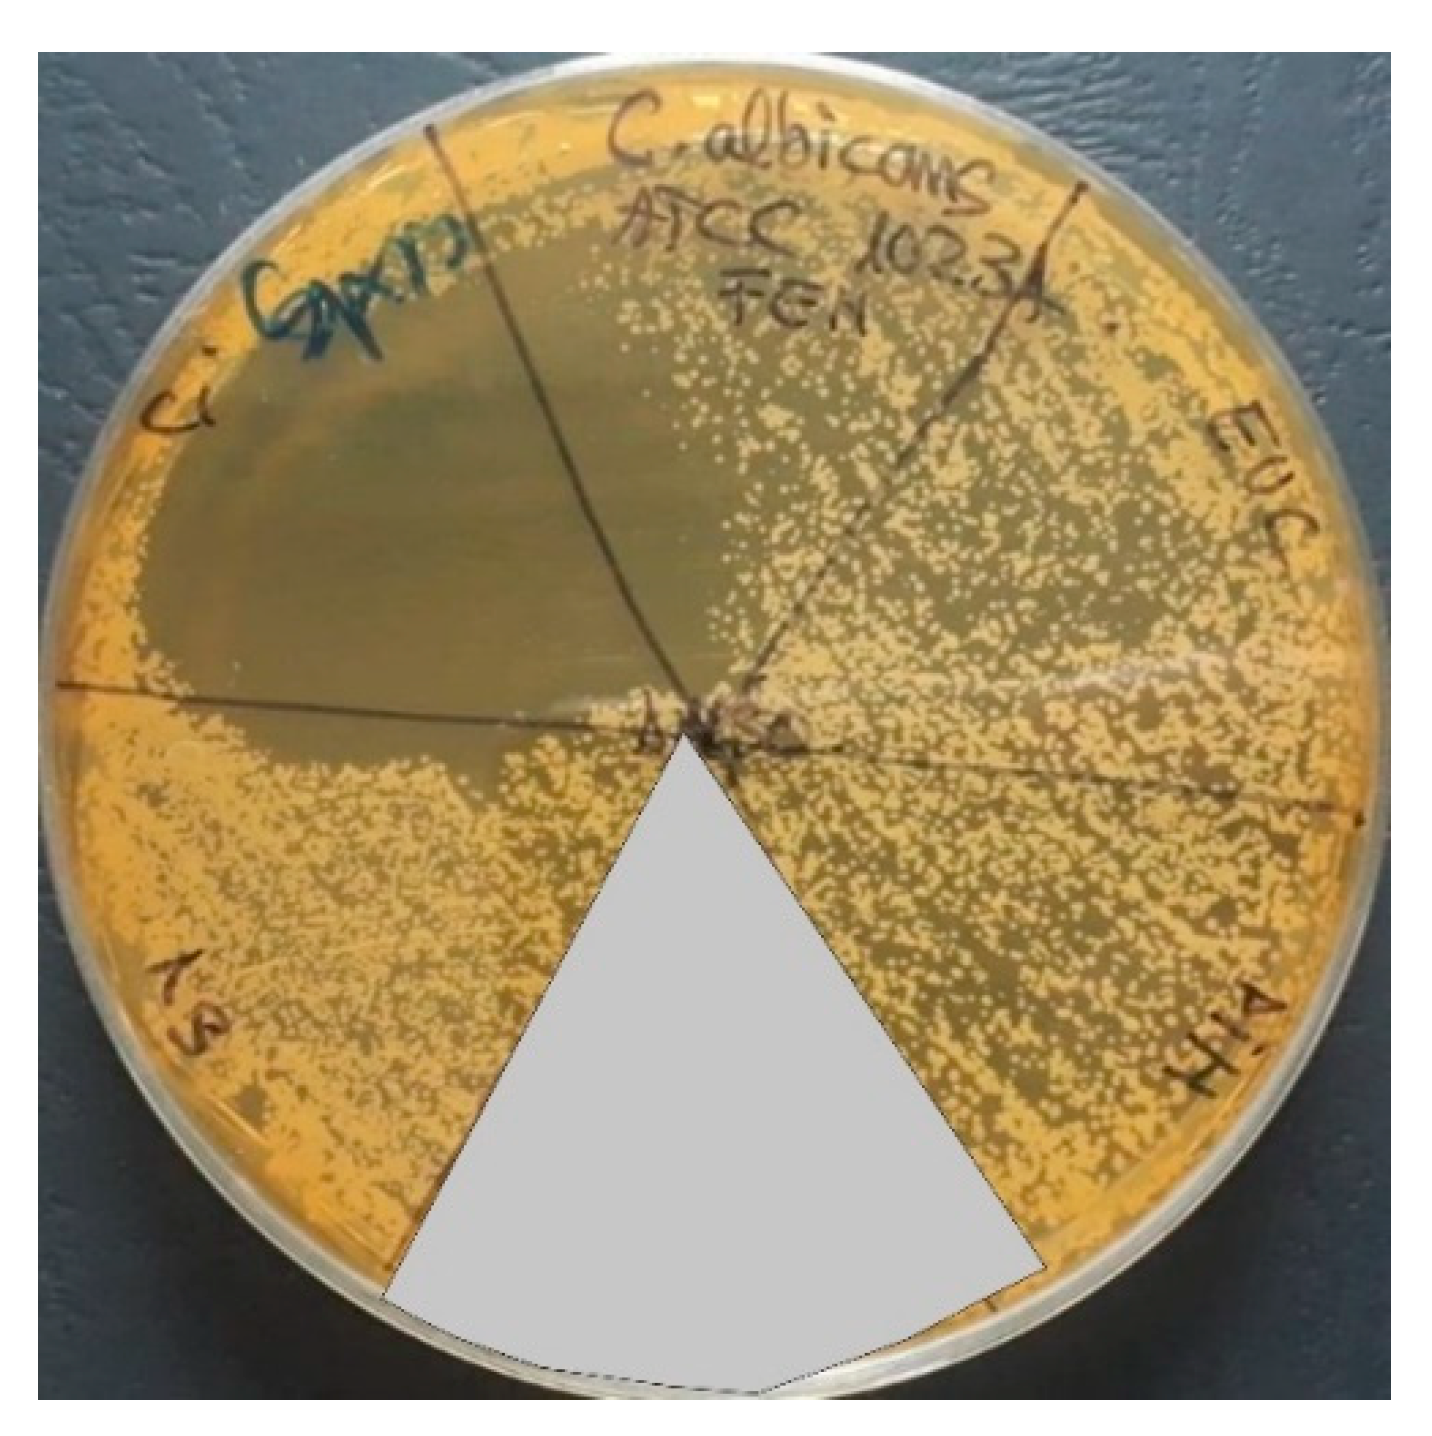
Applsci 12 09482 g006 Applsci 12 09482 g006

In Vitro Antibacterial Activity of Some Plant Essential Oils against Four Different Microbial Strains
Abstract
1. Introduction
2. Materials and Methods
2.1. Obtaining Oils
2.2. Physical-Chemical Parameters of the Essential Oils
2.3. Antimicrobial Activities of the Essential Oils
3. Results and Discussion
3.1. Physical-Chemical Parameters of the Essential Oils
3.2. Antimicrobial Activities of the Essential Oils
4. Conclusions
Author Contributions
Funding
Institutional Review Board Statement
Informed Consent Statement
Data Availability Statement
Conflicts of Interest
References
- Carneiro, J.N.P.; da Cruz, R.P.; Campina, F.F.; Costa, M.d.S.; dos Santos, A.T.L.; Sales, D.L.; Bezerra, C.F.; da Silva, L.E.; de Araujo, J.P.; do Amaral, W.; et al. GC/MS Analysis and Antimicrobial Activity of the Piper Mikanianum (Kunth) Steud. Essential Oil. Food Chem. Toxicol. 2020, 135, 110987. [Google Scholar] [CrossRef] [PubMed]
- Mahboubi, M. Mentha Spicata as Natural Analgesia for Treatment of Pain in Osteoarthritis Patients. Complement. Ther. Clin. Pract. 2017, 26, 1–4. [Google Scholar] [CrossRef] [PubMed]
- Oliva, A.; Costantini, S.; de Angelis, M.; Garzoli, S.; Božović, M.; Mascellino, M.T.; Vullo, V.; Ragno, R. High Potency of Melaleuca Alternifolia Essential Oil against Multi-Drug Resistant Gram-Negative Bacteria and Methicillin-Resistant Staphylococcus Aureus. Molecules 2018, 23, 2584. [Google Scholar] [CrossRef] [PubMed]
- Wińska, K.; Mączka, W.; Łyczko, J.; Grabarczyk, M.; Czubaszek, A.; Szumny, A. Essential Oils as Antimicrobial Agents—Myth or Real Alternative? Molecules 2019, 24, 2130. [Google Scholar] [CrossRef] [PubMed]
- Burt, S. Essential Oils: Their Antibacterial Properties and Potential Applications in Foods—A Review. Int. J. Food Microbiol. 2004, 94, 223–253. [Google Scholar] [CrossRef] [PubMed]
- Aruoma, O.I. Free Radicals, Oxidative Stress, and Antioxidants in Human Health and Disease. J. Am. Oil Chem. Soc. 1998, 75, 199–212. [Google Scholar] [CrossRef]
- Marinescu, R.; Antoniac, I.; Laptoiu, D.; Antoniac, A.; Grecu, D. Complications Related to Biocomposite Screw Fixation in ACL Reconstruction Based on Clinical Experience and Retrieval Analysis. Mater. Plast. 2015, 52, 340–344. [Google Scholar]
- Gheorghe, D.; Pop, D.M.; Ciocoiu, R.; Trante, O.; Milea, C.; Mohan, A.G.; Benea, H.; Saceleanu, V. Microstructure Development in Titanium and Its Alloys Used for Medical Applications. UPB Sci. Bull. Ser. B Chem. Mater. Sci. 2019, 81, 244–258. [Google Scholar]
- Baltatu, I.; Sandu, A.V.; Vlad, M.D.; Spataru, M.C.; Vizureanu, P.; Baltatu, M.S. Mechanical Characterization and In Vitro Assay of Biocompatible Titanium Alloys. Micromachines 2022, 13, 430. [Google Scholar] [CrossRef] [PubMed]
- Perju, M.C.; Nejneru, C.; Vizureanu, P.; Aelenei, A.A.; Sandu, A.; Sachelarie, L.; Nabialek, M. Some Aspects Concerning Titanium Coverage with Hydroxyapatite. Arch. Metall. Mater. 2022, 67, 521–527. [Google Scholar] [CrossRef]
- Vizureanu, P.; Yamaguchi, S.; Le, P.T.M.; Baltatu, M.S. Biocompatibility Evaluation of New Timosi Alloys. In Proceedings of the Applications of Physics in Mechanical and Material Engineering APMME 2020, Częstochowa, Poland, 1 August 2020; Volume 138, pp. 283–286. [Google Scholar]
- Robu, A.; Antoniac, A.; Grosu, E.; Vasile, E.; Raiciu, A.D.; Iordache, F.; Antoniac, V.I.; Rau, J.V.; Yankova, V.G.; Ditu, L.M.; et al. Additives Imparting Antimicrobial Properties to Acrylic Bone Cements. Materials 2021, 14, 7031. [Google Scholar] [CrossRef] [PubMed]
- Pantea, M.; Antoniac, I.; Trante, O.; Ciocoiu, R.; Fischer, C.A.; Traistaru, T. Correlations between Connector Geometry and Strength of Zirconia-Based Fixed Partial Dentures. Mater. Chem. Phys. 2019, 222, 96–109. [Google Scholar] [CrossRef]
- Cavalu, S.; Antoniac, I.V.; Mohan, A.; Bodog, F.; Doicin, C.; Mates, I.; Ulmeanu, M.; Murzac, R.; Semenescu, A. Nanoparticles and Nanostructured Surface Fabrication for Innovative Cranial and Maxillofacial Surgery. Materials 2020, 13, 5391. [Google Scholar] [CrossRef]
- Mavrodin, C.I.; Pariza, G.; Ion, D.; Antoniac, V.I. Abdominal Compartment Syndrome—A Major Complication of Large Incisional Hernia Surgery. Chirurgia 2015, 108, 414–417. [Google Scholar]
- Pariza, G.; Mavrodin, C.; Antoniac, I. Dependency Between the Porosity and Polymeric Structure of Biomaterials Used in Hernia Surgery and Chronic Mesh—Infection. Mater. Plast. 2015, 52, 484–486. [Google Scholar]
- Manescu, V.; Paltanea, G.; Antoniac, I.; Vasilescu, M. Magnetic Nanoparticles Used in Oncology. Materials 2021, 14, 5948. [Google Scholar] [CrossRef]
- Moldovan, H.; Gheorghita, D.; Antoniac, I.; Gheorghe, D.; Fiori, F.; Mohan, A.; Raftu, G.; Ionel, C.; Costache, V. Bioadhesives Used in Cardiovascular Surgery. Rev. De Chim. 2018, 69, 2799–2803. [Google Scholar] [CrossRef]
- Costache, V.S.; Meekel, J.P.; Costache, A.; Melnic, T.; Solomon, C.; Chitic, A.M.; Bucurenciu, C.; Moldovan, H.; Antoniac, I.; Candea, G.; et al. Geometric Analysis of Type B Aortic Dissections Shows Aortic Remodeling After Intervention Using Multilayer Stents. Materials 2020, 13, 2274. [Google Scholar] [CrossRef] [PubMed]
- Maddheshiya, S.; Ahmad, A.; Ahmad, W.; Zakir, F.; Aggarwal, G. Essential Oils for the Treatment of Skin Anomalies: Scope and Potential. South Afr. J. Bot. 2022; in press. [Google Scholar]
- Tabassum, N.; Hamdani, M. Plants Used to Treat Skin Diseases. Pharmacogn. Rev. 2014, 8, 52–60. [Google Scholar] [CrossRef] [PubMed]
- Yoon, W.-J.; Kim, S.-S.; Oh, T.-H.; Lee, N.H.; Hyun, C.-G. Abies Koreana Essential Oil Inhibits Drug-Resistant Skin Pathogen Growth and LPS-Induced Inflammatory Effects of Murine Macrophage. Lipids 2009, 44, 471–476. [Google Scholar] [CrossRef]
- Can, K.H.; Demirci, B.; Iscan, G.; Hashimoto, T.; Demirci, F.; Noma, Y.; Asakawa, Y. The Essential Oil Constituents and Antimicrobial Activity of Anthemis Aciphylla BOISS. Var. Discoidea BOISS; Chem. Pharm. Bull. 2006, 54, 222–225. [Google Scholar]
- Hsouna, A.; Hamdi, N.; Halima, N.B.; Abdelkafi, S. Characterization of Essential Oil from Citrus Aurantium L. Flowers: Antimicrobial and Antioxidant Activities. J. Oleo Sci. 2013, 62, 763–772. [Google Scholar] [CrossRef]
- Hamoud, R.; Sporer, F.; Reichling, J.; Wink, M. Antimicrobial Activity of a Traditionally Used Complex Essential Oil Distillate (Olbas® Tropfen) in Comparison to Its Individual Essential Oil Ingredients. Phytomedicine 2012, 19, 969–976. [Google Scholar] [CrossRef]
- Mota, A.S.; Martins, M.R.; Arantes, S.; Lopes, V.R.; Bettencourt, E.; Pombal, S.; Gomes, A.C.; Silva, L.A. Antimicrobial Activity and Chemical Composition of the Essential Oils of Portuguese Foeniculum Vulgare Fruits. Nat. Prod. Commun 2015, 10, 673–676. [Google Scholar] [CrossRef]
- Cardile, V.; Russo, A.; Formisano, C.; Rigano, D.; Senatore, F.; Arnold, N.A.; Piozzi, F. Essential Oils of Salvia Bracteata and Salvia Rubifolia from Lebanon: Chemical Composition, Antimicrobial Activity and Inhibitory Effect on Human Melanoma Cells. J. Ethnopharmacol. 2009, 126, 265–272. [Google Scholar] [CrossRef]
- de Rapper, S.; Kamatou, G.; Viljoen, A.; van Vuuren, S. The in Vitro Antimicrobial Activity of Lavandula Angustifolia Essential Oil in Combination with Other Aroma-Therapeutic Oils. Evid.-Based Complement. Altern. Med. 2013, 2013, 852049. [Google Scholar] [CrossRef]
- Daaboul, H.E.; Dagher, C.; Taleb, R.I.; Bodman-Smith, K.; Shebaby, W.N.; El-Sibai, M.; Mroueh, M.A.; Daher, C.F. The Chemotherapeutic Effect of β-2-Himachalen-6-Ol in Chemically Induced Skin Tumorigenesis. Biomed. Pharmacother. 2018, 103, 443–452. [Google Scholar] [CrossRef]
- Shiva Kumar, A.; Jeyaprakash, K.; Chellappan, D.R.; Murugan, R. Vasorelaxant and Cardiovascular Properties of the Essential Oil of Pogostemon Elsholtzioides. J. Ethnopharmacol. 2017, 199, 86–90. [Google Scholar] [CrossRef]
- Adefegha, S.A.; Olasehinde, T.A.; Oboh, G. Essential oil composition, antioxidant, antidiabetic and antihypertensive properties of two Afromomum species. J. Oleo Sci. 2017, 66, 51–63. [Google Scholar] [CrossRef]
- Singh, V.; Jain, M.; Misra, A.; Khanna, V.; Rana, M.; Prakash, P.; Malasoni, R.; Dwivedi, A.K.; Dikshit, M.; Barthwal, M.K. Curcuma Oil Ameliorates Hyperlipidaemia and Associated Deleterious Effects in Golden Syrian Hamsters. Br. J. Nutr. 2013, 110, 437–446. [Google Scholar] [CrossRef]
- Lin, L.-Y.; Chuang, C.-H.; Chen, H.-C.; Yang, K.-M. Lime (Citrus Aurantifolia (Christm.) Swingle) Essential Oils: Volatile Compounds, Antioxidant Capacity, and Hypolipidemic Effect. Foods 2019, 8, 398. [Google Scholar] [CrossRef] [PubMed]
- Koubaa-Ghorbel, F.; Chaâbane, M.; Turki, M.; Makni-Ayadi, F.; el Feki, A. The Protective Effects of Salvia Officinalis Essential Oil Compared to Simvastatin against Hyperlipidemia, Liver, and Kidney Injuries in Mice Submitted to a High-fat Diet. J. Food Biochem. 2020, 44, e13160. [Google Scholar] [CrossRef]
- Moslemi, F.; Alijaniha, F.; Naseri, M.; Kazemnejad, A.; Charkhkar, M.; Heidari, M.R. Citrus Aurantium Aroma for Anxiety in Patients with Acute Coronary Syndrome: A Double-Blind Placebo-Controlled Trial. J. Altern. Complement. Med. 2019, 25, 833–839. [Google Scholar] [CrossRef]
- Song, E.J.; Lee, M.Y. Effects of Aromatherapy on Stress Responses, Autonomic Nervous System Activity and Blood Pressure in the Patients Undergoing Coronary Angiography: A Non-Randomized Controlled Trial. J. Korean Acad. Nurs. 2018, 48, 1. [Google Scholar] [CrossRef]
- Elbahnasawy, A.S.; Valeeva, E.R.; El-Sayed, E.M.; Rakhimov, I.I. The Impact of Thyme and Rosemary on Prevention of Osteoporosis in Rats. J. Nutr. Metab. 2019, 2019, 1431384. [Google Scholar] [CrossRef]
- Sapkota, M.; Li, L.; Kim, S.-W.; Soh, Y. Thymol Inhibits RANKL-Induced Osteoclastogenesis in RAW264.7 and BMM Cells and LPS-Induced Bone Loss in Mice. Food Chem. Toxicol. 2018, 120, 418–429. [Google Scholar] [CrossRef]
- Belkhodja, H.; Meddah, B.; Meddah TirTouil, A.; Sli.imani, K.; Tou, A. Radiographic and Histopathologic Analysis on Osteoarthritis Rat Model Treated with Essential Oils of Rosmarinus Officinalis and Populus Alba. Pharm. Sci. 2017, 23, 12–17. [Google Scholar] [CrossRef]
- Funk, J.L.; Frye, J.B.; Oyarzo, J.N.; Chen, J.; Zhang, H.; Timmermann, B.N. Anti-Inflammatory Effects of the Essential Oils of Ginger (Zingiber Officinale Roscoe) in Experimental Rheumatoid Arthritis. PharmaNutrition 2016, 4, 123–131. [Google Scholar] [CrossRef]
- Xu, C.; Sheng, S.; Dou, H.; Chen, J.; Zhou, K.; Lin, Y.; Yang, H. α-Bisabolol Suppresses the Inflammatory Response and ECM Catabolism in Advanced Glycation End Products-Treated Chondrocytes and Attenuates Murine Osteoarthritis. Int. Immunopharmacol. 2020, 84, 106530. [Google Scholar] [CrossRef]
- Gomes, B.S.; Neto, B.P.S.; Lopes, E.M.; Cunha, F.V.M.; Araújo, A.R.; Wanderley, C.W.S.; Wong, D.V.T.; Júnior, R.C.P.L.; Ribeiro, R.A.; Sousa, D.P.; et al. Anti-Inflammatory Effect of the Monoterpene Myrtenol Is Dependent on the Direct Modulation of Neutrophil Migration and Oxidative Stress. Chem. Biol. Interact. 2017, 273, 73–81. [Google Scholar] [CrossRef]
- BI, J.-P.; LI, P.; XU, X.-X.; WANG, T.; LI, F. Anti-Rheumatoid Arthritic Effect of Volatile Components in Notopterygium Incisum in Rats via Anti-Inflammatory and Anti-Angiogenic Activities. Chin. J. Nat. Med. 2018, 16, 926–935. [Google Scholar] [CrossRef]
- Nasiri, A.; Mahmodi, M.A.; Nobakht, Z. Effect of Aromatherapy Massage with Lavender Essential Oil on Pain in Patients with Osteoarthritis of the Knee: A Randomized Controlled Clinical Trial. Complement. Ther. Clin. Pract. 2016, 25, 75–80. [Google Scholar] [CrossRef]
- Miranda, L.L.; Guimarães-Lopes, V.d.P.; Altoé, L.S.; Sarandy, M.M.; Melo, F.C.S.A.; Novaes, R.D.; Gonçalves, R.V. Plant Extracts in the Bone Repair Process: A Systematic Review. Mediat. Inflamm. 2019, 2019, 1296153. [Google Scholar] [CrossRef]
- Damlar, İ.; Arpağ, O.F.; Tatli, U.; Altan, A. Effects of Hypericum Perforatum on the Healing of Xenografts: A Histomorphometric Study in Rabbits. Br. J. Oral Maxillofac. Surg. 2017, 55, 383–387. [Google Scholar] [CrossRef]
- Chircov, C.; Miclea, I.I.; Grumezescu, V.; Grumezescu, A.M. Essential Oils for Bone Repair and Regeneration—Mechanisms and Applications. Materials 2021, 14, 1867. [Google Scholar] [CrossRef]
- Maver, T.; Kurečič, M.; Maja Smrke, D.; Stana Kleinschek, K.; Maver, U. Plant-Derived Medicines with Potential Use in Wound Treatment. In Herbal Medicine; IntechOpen: London, UK, 2019. [Google Scholar]
- Dauqan, E.M.; Abdullah, A. Medicinal and Functional Values of Thyme (Thymus vulgaris L.) Herb. J. Appl. Biol. Biotechnol. 2017, 5, 17–22. [Google Scholar] [CrossRef]
- Dursun, N.; Liman, N.; Özyazgan, İ.; Güneş, I.; Saraymen, R. Role of Thymus Oil in Burn Wound Healing. J. Burn Care Rehabil. 2003, 24, 395–399. [Google Scholar] [CrossRef]
- Komarcević, A. The Modern Approach to Wound Treatment. Med. Pregl. 2000, 53, 363–368. [Google Scholar]
- Bozin, B.; Mimica-Dukic, N.; Simin, N.; Anackov, G. Characterization of the Volatile Composition of Essential Oils of Some Lamiaceae Spices and the Antimicrobial and Antioxidant Activities of the Entire Oils. J. Agric. Food Chem. 2006, 54, 1822–1828. [Google Scholar] [CrossRef]
- Shin, S.; Kim, J.H. In Vitro Inhibitory Activities of Essential Oils from Two Korean Thymus Species against Antibiotic-Resistant Pathogens. Arch. Pharmacal Res. 2005, 28, 897–901. [Google Scholar] [CrossRef]
- Balahbib, A.; el Omari, N.; Hachlafi, N.; Lakhdar, F.; el Menyiy, N.; Salhi, N.; Mrabti, H.N.; Bakrim, S.; Zengin, G.; Bouyahya, A. Health Beneficial and Pharmacological Properties of P-Cymene. Food Chem. Toxicol. 2021, 153, 112259. [Google Scholar] [CrossRef]
- Bilenler, T.; Gokbulut, I.; Sislioglu, K.; Karabulut, I. Antioxidant and Antimicrobial Properties of Thyme Essential Oil Encapsulated in Zein Particles. Flavour Fragr. J. 2015, 30, 392–398. [Google Scholar] [CrossRef]
- Sousa, L.G.V.; Castro, J.; Cavaleiro, C.; Salgueiro, L.; Tomás, M.; Palmeira-Oliveira, R.; Martinez-Oliveira, J.; Cerca, N. Synergistic Effects of Carvacrol, α-Terpinene, γ-Terpinene, ρ-Cymene and Linalool against Gardnerella Species. Sci. Rep. 2022, 12, 4417. [Google Scholar] [CrossRef]
- El-Guendouz, S.; Aazza, S.; Dandlen, S.A.; Majdoub, N.; Lyoussi, B.; Raposo, S.; Antunes, M.D.; Gomes, V.; Miguel, M.G. Antioxidant Activity of Thyme Waste Extract in O/W Emulsions. Antioxidants 2019, 8, 243. [Google Scholar] [CrossRef]
- Amorati, R.; Foti, M.C.; Valgimigli, L. Antioxidant Activity of Essential Oils. J. Agric. Food Chem. 2013, 61, 10835–10847. [Google Scholar] [CrossRef]
- Tepe, B.; Sokmen, M.; Akpulat, H.A.; Daferera, D.; Polissiou, M.; Sokmen, A. Antioxidative Activity of the Essential Oils of Thymus Sipyleus Subsp. Sipyleus Var. Sipyleus and Thymus Sipyleus Subsp. Sipyleus Var. Rosulans. J. Food Eng. 2005, 66, 447–454. [Google Scholar] [CrossRef]
- Vardar-Ünlü, G.; Candan, F.; Sókmen, A.; Daferera, D.; Polissiou, M.; Sökmen, M.; Dönmez, E.; Tepe, B. Antimicrobial and Antioxidant Activity of the Essential Oil and Methanol Extracts of Thymus Pectinatus Fisch. et Mey. Var. Pectinatus (Lamiaceae). J. Agric. Food Chem. 2003, 51, 63–67. [Google Scholar] [CrossRef]
- Salehi, B.; Mishra, A.P.; Shukla, I.; Sharifi-Rad, M.; Contreras, M.d.M.; Segura-Carretero, A.; Fathi, H.; Nasrabadi, N.N.; Kobarfard, F.; Sharifi-Rad, J. Thymol, Thyme, and Other Plant Sources: Health and Potential Uses. Phytother. Res. 2018, 32, 1688–1706. [Google Scholar] [CrossRef]
- Pandur, E.; Micalizzi, G.; Mondello, L.; Horváth, A.; Sipos, K.; Horváth, G. Antioxidant and Anti-Inflammatory Effects of Thyme (Thymus Vulgaris L.) Essential Oils Prepared at Different Plant Phenophases on Pseudomonas Aeruginosa LPS-Activated THP-1 Macrophages. Antioxidants 2022, 11, 1330. [Google Scholar] [CrossRef]
- Pinto, E.; Salgueiro, L.R.; Cavaleiro, C.; Palmeira, A.; Gonçalves, M.J. In Vitro Susceptibility of Some Species of Yeasts and Filamentous Fungi to Essential Oils of Salvia Officinalis. Ind. Crops Prod. 2007, 26, 135–141. [Google Scholar] [CrossRef]
- Abu-Darwish, M.S.; Cabral, C.; Ferreira, I.; Gonçalves, M.J.; Cavaleiro, C.; Cruz, M.T.; Al-Bdour, T.H.; Salgueiro, L. Essential Oil of Common Sage (Salvia Officinalis L.) from Jordan: Assessment of Safety in Mammalian Cells and Its Antifungal and Anti-Inflammatory Potential. Biomed. Res. Int. 2013, 2013, 538940. [Google Scholar] [CrossRef] [PubMed]
- ben Farhat, M.; Jordán, M.J.; Chaouech-Hamada, R.; Landoulsi, A.; Sotomayor, J.A. Variations in Essential Oil, Phenolic Compounds, and Antioxidant Activity of Tunisian Cultivated Salvia Officinalis L. J. Agric Food Chem. 2009, 57, 10349–10356. [Google Scholar] [CrossRef]
- Ozkan, A.; Erdogan, A.; Sokmen, M.; Tugrulay, S.; Unal, O. Antitumoral and Antioxidant Effect of Essential Oils and in Vitro Antioxidant Properties of Essential Oils and Aqueous Extracts from Salvia Pisidica. Biologia 2010, 65, 990–996. [Google Scholar] [CrossRef]
- Ruberto, G.; Baratta, M.T. Antioxidant Activity of Selected Essential Oil Components in Two Lipid Model Systems. Food Chem 2000, 69, 167–174. [Google Scholar] [CrossRef]
- Msaada, K.; Salem, N.; Bachrouch, O.; Bousselmi, S.; Tammar, S.; Alfaify, A.; al Sane, K.; ben Ammar, W.; Azeiz, S.; Haj Brahim, A.; et al. Chemical Composition and Antioxidant and Antimicrobial Activities of Wormwood (Artemisia Absinthium L.) Essential Oils and Phenolics. J. Chem. 2015, 2015, 804658. [Google Scholar] [CrossRef]
- Msaada, K.; Hosni, K.; Salem, N. Comparison of Different Extraction Methods for the Determination of Essential Oils and Related Compounds from Coriander (Coriandrum Sativum L.) Characterization of Bioactive Molecules Produced by Novel Streptomyces Strains View Project. Anal. Bioanal. Chem. 2014, 387, 2207–2217. [Google Scholar]
- Joshi, H.; Parle, M. Cholinergic Basis of Memory-Strengthening Effect of Foeniculum Vulgare Linn. J. Med. Food 2006, 9, 413–417. [Google Scholar] [CrossRef]
- Anwar, F.; Ali, M.; Hussain, A.I.; Shahid, M. Antioxidant and Antimicrobial Activities of Essential Oil and Extracts of Fennel (Foeniculum Vulgare Mill.) Seeds from Pakistan. Flavour. Fragr. J. 2009, 24, 170–176. [Google Scholar] [CrossRef]
- Vecchio, M.G.; Loganes, C.; Minto, C. Beneficial and Healthy Properties of Eucalyptus Plants: A Great Potential Use. Open Agric. J. 2016, 10, 52–57. [Google Scholar] [CrossRef]
- Hirigoyen, A.; Varo-Martinez, M.A.; Rachid-Casnati, C.; Franco, J.; Navarro-Cerrillo, R.M. Stand Characterization of Eucalyptus Spp. Plantations in Uruguay Using Airborne Lidar Scanner Technology. Remote Sens. 2020, 12, 3947. [Google Scholar] [CrossRef]
- Vieira, T.A.S.; Arriel, T.G.; Zanuncio, A.J.V.; Carvalho, A.G.; Branco-Vieira, M.; Carabineiro, S.A.C.; Trugilho, P.F. Determination of the Chemical Composition of Eucalyptus Spp. For Cellulosic Pulp Production. Forests 2021, 12, 1649. [Google Scholar] [CrossRef]
- Mahleyuddin, N.N.; Moshawih, S.; Ming, L.C.; Zulkifly, H.H.; Kifli, N.; Loy, M.J.; Sarker, M.M.R.; Al-Worafi, Y.M.; Goh, B.H.; Thuraisingam, S.; et al. Coriandrum Sativum L.: A Review on Ethnopharmacology, Phytochemistry, and Cardiovascular Benefits. Molecules 2021, 27, 209. [Google Scholar] [CrossRef] [PubMed]
- Salem, M.Z.M.; Ashmawy, N.A.; Elansary, H.O.; El-Settawy, A.A. Chemotyping of Diverse Eucalyptus Species Grown in Egypt and Antioxidant and Antibacterial Activities of Its Respective Essential Oils. Nat. Prod. Res. 2015, 29, 681–685. [Google Scholar] [CrossRef] [PubMed]
- Silori, G.K.; Kushwaha, N.; Kumar, V. Essential Oils from Pines: Chemistry and Applications. In Essential Oil Research; Springer: Cham, Switzerland, 2019; pp. 275–297. [Google Scholar] [CrossRef]
- Bhalla, B.; Saini, M.S.; Jha, M.K. Effect of Age and Seasonal Variation on Leachate Characteristics of Municipal Solid Waste Landfill. Int. J. Res. Eng. Technol. 2013, 02, 223–232. [Google Scholar] [CrossRef]
- Theis, N.; Lerdau, M. The Evolution of Function in Plant Secondary Metabolites. Int. J. Plant Sci. 2003, 164, S93–S102. [Google Scholar] [CrossRef]
- Cox-Georgian, D.; Ramadoss, N.; Dona, C.; Basu, C. Therapeutic and Medicinal Uses of Terpenes. In Medicinal Plants: From Farm to Pharmacy; Springer: Cham, Switzerland, 2019; pp. 333–359. ISBN 9783030312695. [Google Scholar] [CrossRef]
- Moreira, M.R.; Ponce, A.G.; del Valle, C.E.; Roura, S.I. Inhibitory Parameters of Essential Oils to Reduce a Foodborne Pathogen. LWT Food Sci. Technol. 2005, 38, 565–570. [Google Scholar] [CrossRef]
- Jeong, M.S.; Park, S.J.; Han, E.J.; Park, S.Y.; Kim, M.J.; Jung, K.; Cho, S.H.; Kim, S.Y.; Yoon, W.J.; Ahn, G.; et al. Pinus Thunbergii PARL Leaf Protects against Alcohol-Induced Liver Disease by Enhancing Antioxidant Defense Mechanism in BALB/c Mice. J. Funct. Foods 2020, 73, 104116. [Google Scholar] [CrossRef]
- Koutsaviti, A.; Toutoungy, S.; Saliba, R.; Loupassaki, S.; Tzakou, O.; Roussis, V.; Ioannou, E. Antioxidant Potential of Pine Needles: A Systematic Study on the Essential Oils and Extracts of 46 Species of the Genus Pinus. Foods 2021, 10, 142. [Google Scholar] [CrossRef]
- Mármol, I.; Quero, J.; Jiménez-Moreno, N.; Rodríguez-Yoldi, M.J.; Ancín-Azpilicueta, C. A Systematic Review of the Potential Uses of Pine Bark in Food Industry and Health Care. Trends Food Sci. Technol. 2019, 88, 558–566. [Google Scholar] [CrossRef]
- Xie, Q.; Liu, Z.; Li, Z. Chemical Composition and Antioxidant Activity of Essential Oil of Six Pinus Taxa Native to China. Molecules 2015, 20, 9380–9392. [Google Scholar] [CrossRef]
- Zeng, W.-C.; Zhang, Z.; Gao, H.; Jia, L.-R.; He, Q. Chemical Composition, Antioxidant, and Antimicrobial Activities of Essential Oil from Pine Needle (Cedrus Deodara). J. Food Sci. 2012, 77, C824–C829. [Google Scholar] [CrossRef] [PubMed]
- ISO279:1998—Essential Oils-Determination of Relative Density at 20 °C-Reference Method; ISO: Geneva, Switzerland, 1998.
- Council of Europe; European Pharmacopoeia Commission; European Directorate for the Quality of Medicines & Healthcare EDQM. European Pharmacopoeia; Council of Europe: Strasbourg, France, 2013; ISBN 9789287189127. [Google Scholar]
- Benzie, I.F.F.; Strain, J.J. The Ferric Reducing Ability of Plasma (FRAP) as a Measure of “Antioxidant Power”: The FRAP Assay. Anal. Biochem. 1996, 239, 70–76. [Google Scholar] [CrossRef]
- Gaspar-Pintiliescu, A.; Popescu, A.F. Antioxidant and Acetylcholinesterase Inhibition Capacity of Hyrosols from Lamiaceae Plants for Biopesticide Use. The Role of Phenolic Compounds. Res. Sq. 2022. [Google Scholar] [CrossRef]
- Fierascu, I.; Ditu, L.M.; Sutan, A.N.; Drăghiceanu, O.A.; Fierascu, R.C.; Avramescu, S.M.; Lungulescu, E.M.; Nicula, N.; Soare, L.C. Influence of Gamma Irradiation on the Biological Properties of Asplenium Scolopendrium L. Hydroalcoholic Extracts. Radiat. Phys. Chem. 2021, 181, 109175. [Google Scholar] [CrossRef]
- Caldefie-Chézet, F.; Guerry, M.; Chalchat, J.-C.; Fusillier, C.; Vasson, M.-P.; Guillot, J. Anti-Inflammatory Effects of Melaleuca Alternifolia Essential Oil on Human Polymorphonuclear Neutrophils and Monocytes. Free Radic. Res. 2004, 38, 805–811. [Google Scholar] [CrossRef] [PubMed]
- Dhifi, W.; Bellili, S.; Jazi, S.; Bahloul, N.; Mnif, W. Essential Oils’ Chemical Characterization and Investigation of Some Biological Activities: A Critical Review. Medicines 2016, 3, 25. [Google Scholar] [CrossRef] [PubMed]
- Galili, S.; Hovav, R. Determination of Polyphenols, Flavonoids, and Antioxidant Capacity in Dry Seeds. In Polyphenols in Plants; Elsevier: Amsterdam, The Netherlands, 2014; pp. 305–323. [Google Scholar]
- de Christo Scherer, M.M.; Marques, F.M.; Figueira, M.M.; Peisino, M.C.O.; Schmitt, E.F.P.; Kondratyuk, T.P.; Endringer, D.C.; Scherer, R.; Fronza, M. Wound Healing Activity of Terpinolene and α-Phellandrene by Attenuating Inflammation and Oxidative Stress in Vitro. J. Tissue Viability 2019, 28, 94–99. [Google Scholar] [CrossRef] [PubMed]
- Ilijeva, R.; Buchbauer, G. Biological Properties of Some Volatile Phenylpropanoids. Nat. Prod. Commun. 2016, 11, 1619–1629. [Google Scholar] [CrossRef]
- Puškárová, A.; Bučková, M.; Kraková, L.; Pangallo, D.; Kozics, K. The Antibacterial and Antifungal Activity of Six Essential Oils and Their Cyto/Genotoxicity to Human HEL 12469 Cells. Sci. Rep. 2017, 7, 8211. [Google Scholar] [CrossRef]
- Semeniuc, C.A.; Pop, C.R.; Rotar, A.M. Antibacterial Activity and Interactions of Plant Essential Oil Combinations against Gram-Positive and Gram-Negative Bacteria. J. Food Drug Anal. 2017, 25, 403–408. [Google Scholar] [CrossRef]
- Tampieri, M.P.; Galuppi, R.; Macchioni, F.; Carelle, M.S.; Falcioni, L.; Cioni, P.L.; Morelli, I. The Inhibition of Candida Albicans by Selected Essential Oils and Their Major Components. Mycopathologia 2005, 159, 339–345. [Google Scholar] [CrossRef]
- Xiao, S.; Cui, P.; Shi, W.; Zhang, Y. Identification of Essential Oils with Activity against Stationary Phase Staphylococcus Aureus. BMC Complement. Med. 2020, 20, 99. [Google Scholar] [CrossRef] [PubMed]
- Sharifi, A.; Mohammadzadeh, A.; Zahraei Salehi, T.; Mahmoodi, P. Antibacterial, Antibiofilm and Antiquorum Sensing Effects of Thymus Daenensis and Satureja Hortensis Essential Oils against Staphylococcus Aureus Isolates. J. Appl. Microbiol. 2018, 124, 379–388. [Google Scholar] [CrossRef] [PubMed]
- Cui, H.; Zhang, X.; Zhou, H.; Zhao, C.; Lin, L. Antimicrobial Activity and Mechanisms of Salvia Sclarea Essential Oil. Bot. Stud. 2015, 56, 16. [Google Scholar] [CrossRef] [PubMed]

| Code | Type of EO | The Vegetable Material from Which the Oil Is Extracted | The Origin of the Vegetable Raw Material |
|---|---|---|---|
| FEN | Fennel essential oil (Foeniculum vulgare) | Aerial parts | S.C.Hofigal S.A |
| SV | Sage essential oil (Salvia officinalis) | Aerial parts | S.C.Hofigal S.A |
| EUC | Eucalyptus essential oil (Eucalyptus sp.) | Leaf | Import |
| CI | Thyme essential oil (Satureja hortensis L.) | Aerial parts | S.C.Hofigal S.A |
| PIN | Pine essential oil (Pinus sylvestris) | Leaf | Spontaneous flora |
| No. | Microbial Strain | Source |
|---|---|---|
| 1 | Staphylococcus aureus ATCC 25923 | Gram-positive standard strain, The microorganism collection of the Microbiology, Department, Faculty of Biology, University of Bucharest |
| 2 | Pseudomonas aeruginosa ATCC 27853 | Gram-negative standard strain, The microorganism collection of the Microbiology, Department, Faculty of Biology, University of Bucharest |
| 3 | Escherichia coli ATCC 25922 | Gram-negative standard strain, The microorganism collection of the Microbiology, Department, Faculty of Biology, University of Bucharest |
| 4 | Candida albicans ATCC 10231 | Yeast standard strain, The microorganism collection of the Microbiology, Department, Faculty of Biology, University of Bucharest |
| Essential Oils | Fennel EO (FEN) | Sage EO (SV) | Eucalyptus EO (EUC) | Thyme EO (CI) | Pine EO (PIN) |
|---|---|---|---|---|---|
| Relative density [g/cm3] | 0.96 | 0.89 | 0.90 | 0.91 | 0.85 |
| Refractive index, λ [nm] | 1.528 | 1.456 | 1.458 | 1.495 | 1.465 |
| Antioxidant activity (mg equivalent to Fe2SO4x 7H2O/g for sample) | 6.09 | 6.54 | 7.09 | 6.79 | 6.49 |
| Compounds | Classes | Eucalyptus EO | Thyme EO | Pine EO | Sage EO | Fennel EO |
|---|---|---|---|---|---|---|
| β-Pinene | MT | 0.36 | - | 30.21 | 1.77 | - |
| α-Phellandrene | MT | 0.51 | - | - | - | 5.66 |
| β-Phellandrene | MT | - | - | 0.60 | - | - |
| β-Myrcene | MT | 0.26 | 0.62 | 2.81 | 0.66 | - |
| D-Limonene | MT | 8.82 | 0.47 | 18.92 | 1.67 | - |
| Eucalyptol | MT | 82.10 | - | - | 7.27 | - |
| γ-Terpinene | MT | 3.36 | 0.29 | - | 0.39 | - |
| p-Cymene | MT | 4.59 | 35.10 | 3.61 | 0.68 | - |
| Camphene | MT | - | 0.71 | 3.15 | 4.28 | - |
| Pinocarvone | MT | - | 2.08 | - | - | - |
| β-Caryophyllene | ST | - | 2.21 | 3.68 | 3.51 | - |
| α-Caryophyllene | ST | - | - | - | 4.44 | - |
| Carvacrol | MT | - | 58.52 | - | - | - |
| Fenchone | MT | - | - | - | - | 11.91 |
| Estragole | PP | - | - | - | - | 2.97 |
| Anethole | PP | - | - | - | - | 79.46 |
| Carene | MT | - | - | 29.08 | - | - |
| Terpinolene | MT | - | - | 0.59 | 0.25 | - |
| Longifolene | ST | - | - | 2.72 | - | - |
| Bornyl acetate | MT | - | - | 3.05 | - | - |
| α-Terpineol | MT | - | - | 1.59 | - | - |
| Thujone | MT | - | - | - | 38.92 | - |
| Isothujone | MT | - | - | - | 6.19 | - |
| (+)-2-Bornanone | MT | - | - | - | 21.32 | - |
| Linalool | MT | - | - | - | 0.72 | - |
| Borneol acetate | MT | - | - | - | 1.01 | - |
| Terpinen-4-ol | MT | - | - | - | 0.56 | - |
| (-) Borneol | MT | - | - | - | 2.55 | - |
| Viridiflorol | ST | - | - | - | 3.82 | - |
| Monoterpene (MT) Sesquiterpene (ST) Phenylpropanoids (PP) | 100 - - | 97.79 2.21 - | 93.6 6.4 - | 88.23 11.77 - | 17.57 - 82.43 |
| Essential Oils/Microbial Strain | Inhibition Zones [mm] | |||
|---|---|---|---|---|
| Escherichia coli ATCC 25922 | Staphylococcus aureus ATCC 25923 | Pseudomonas aeruginosa ATCC 27853 | Candida albicans ATCC 10231 | |
| Fennel EO (FEN) | 16 | 14 | 14 | 0 |
| Sage EO (SV) | 22 | 12 | 19 | 0 |
| Eucalyptus EO (EUC) | 15 | 6 | 11 | 0 |
| Thyme EO (CI) | 30 | 30 | 27 | 35 |
| Pine EO (PIN) | 15 | 0 | 12 | 0 |
| Microbial Strain/Essential Oils | MIC Values [% Dilution in Microbial Culture Media] | ||||
|---|---|---|---|---|---|
| FEN (Fennel EO) | SV (Sage EO) | EUC (Eucalyptus EO) | CI (Thyme EO) | PIN (Pine EO) | |
| Staphylococcus aureus ATCC 25923 | 5% | 2.5% | 2.5% | 1.25% | 10% |
| Pseudomonas aeruginosa ATCC 27853 | 5% | 1.25% | 2.5% | 1.25% | 10% |
| Escherichia coli ATCC 25922 | 5% | 0.156% | 1.25% | 0.625% | 10% |
| Candida albicans ATCC 10231 | 10% | 1.25% | 2.5% | 2.5% | 10% |
Publisher’s Note: MDPI stays neutral with regard to jurisdictional claims in published maps and institutional affiliations. |
© 2022 by the authors. Licensee MDPI, Basel, Switzerland. This article is an open access article distributed under the terms and conditions of the Creative Commons Attribution (CC BY) license (https://creativecommons.org/licenses/by/4.0/).
Share and Cite
Gheorghita, D.; Robu, A.; Antoniac, A.; Antoniac, I.; Ditu, L.M.; Raiciu, A.-D.; Tomescu, J.; Grosu, E.; Saceleanu, A. In Vitro Antibacterial Activity of Some Plant Essential Oils against Four Different Microbial Strains. Appl. Sci. 2022, 12, 9482. https://doi.org/10.3390/app12199482
Gheorghita D, Robu A, Antoniac A, Antoniac I, Ditu LM, Raiciu A-D, Tomescu J, Grosu E, Saceleanu A. In Vitro Antibacterial Activity of Some Plant Essential Oils against Four Different Microbial Strains. Applied Sciences. 2022; 12(19):9482. https://doi.org/10.3390/app12199482
Chicago/Turabian StyleGheorghita, Daniela, Alina Robu, Aurora Antoniac, Iulian Antoniac, Lia Mara Ditu, Anca-Daniela Raiciu, Justinian Tomescu, Elena Grosu, and Adriana Saceleanu. 2022. "In Vitro Antibacterial Activity of Some Plant Essential Oils against Four Different Microbial Strains" Applied Sciences 12, no. 19: 9482. https://doi.org/10.3390/app12199482
APA StyleGheorghita, D., Robu, A., Antoniac, A., Antoniac, I., Ditu, L. M., Raiciu, A.-D., Tomescu, J., Grosu, E., & Saceleanu, A. (2022). In Vitro Antibacterial Activity of Some Plant Essential Oils against Four Different Microbial Strains. Applied Sciences, 12(19), 9482. https://doi.org/10.3390/app12199482

